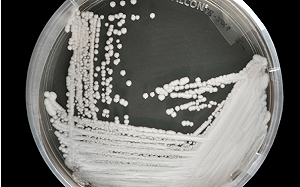
美國爆千人感染耳念珠菌！抗藥性高、1/3患者90天內亡

發布 2023.03.24 11:48
新聞跑馬燈
最新報導
-
 留言
留言 -
 留言
留言發布 2023.03.24 11:46
郭哲敏捉不回來 黃國昌痛批新北地檢永遠不必公佈調查結果?
-

PR
基隆市綠能轉型成效亮眼!油電兼修比例躍升至54%,打造低碳友善新環境
-
 留言
留言發布 2023.03.24 11:45
TikTok執行長出席聽證會!美議員連番「拷問」暗助中共:你們平台應被禁!
-
 留言
留言發布 2023.03.24 11:44
因應央行升息 政院:從兩方面進行協助特定族群
-
 留言
留言發布 2023.03.24 11:44
美國聽證會激烈交鋒!TikTok執行長周受資仍遭質疑
-
 留言
留言發布 2023.03.24 11:30
(影)首批援烏戰機來了!斯洛伐克已交付 德國也趕緊送這個....
-
 留言
留言發布 2023.03.24 11:28
統神兒子是語言天才?晨晨補英文卻「學會了西班牙文」
-
 留言
留言發布 2023.03.24 11:25
(影)大谷翔平好神!賽前一席話風靡全美
-
 留言
留言發布 2023.03.24 11:24
爭取立法院長?柯建銘:下屆我是不是立委還不知道
-
 留言
留言發布 2023.03.24 11:20
月掩金星今晚登場!錯過再等40年
-
 留言
留言發布 2023.03.24 11:16
解婕翎生日認愛知名實況主!網驚呼:姐夫是你
-
 留言
留言發布 2023.03.24 11:15
美國爆千人感染耳念珠菌!抗藥性高、1/3患者90天內亡
-
 留言
留言發布 2023.03.24 11:13
余天「不選」轉戰不分區!民進黨三重立委初選「三腳督」戰況激烈
-
 留言
留言發布 2023.03.24 11:12
狒狒逃脫心累!六福村小編發文崩潰
-
 留言
留言發布 2023.03.24 11:11
蔡政府首長滿意度調查 蔡英文滿意度逾5成、陳吉仲不滿意度破4成
-
 留言
留言發布 2023.03.24 11:09
為了日本棒球未來!栗山英樹道歉
-
 留言 1
留言 1發布 2023.03.24 11:06
習近平、普丁聯合聲明 美防長:發出這個非常令人不安的訊息.....
-
 留言
留言發布 2023.03.24 11:03
南韓斑馬也逃脫!站立車群照片瘋傳
-
 留言 2
留言 2發布 2023.03.24 11:01
高達1/3感染者死亡! CDC :「超級真菌」襲美 一半以上的州淪陷
-
 留言
留言發布 2023.03.24 10:59
日月潭水位直直落!日管處:封閉「玄光碼頭」右側引橋